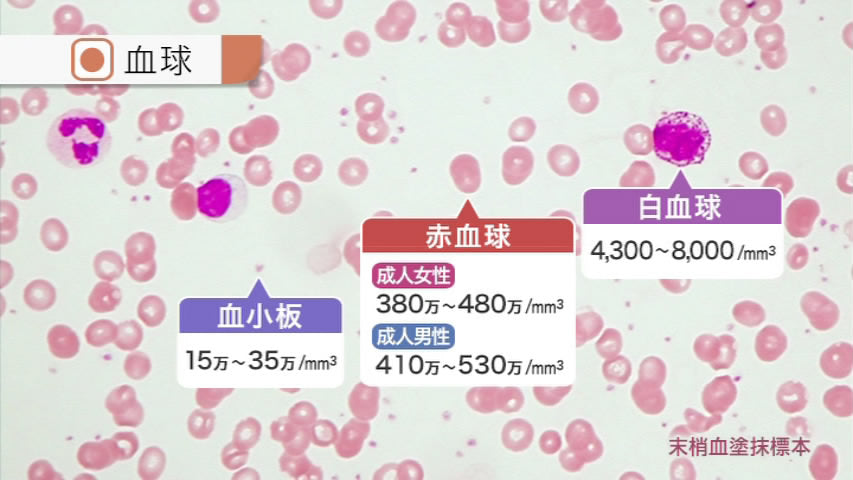

-
- 定価:¥30,800
- オンラインショップ価格:¥29,260
保育カウンセリングは、子どもたちのより良い未来のための心理専門職です。この巻では、保育カウンセリングの理解を深めるために、乳幼児の心身への理解、アセスメント、カウンセリングなど、保育カウンセラーの専門性とその実際について解説します。
Index
●イントロダクション
●保育カウンセリングとは
〇保育カウンセリングの考え方
●保育カウンセリングの専門性I~子どもの心身の状態の理解~
〇子どもの諸問題
〇子どもの心理的状態の理解
●保育カウンセリングの専門性II
〇登園時・降園時
〇作品
〇課題活動
〇食事の時間
●保育カウンセリングの実際
●保護者・保育者との協働
●保育カウンセラーの多様な任務
●エンディング -
- 定価:¥30,800
- オンラインショップ価格:¥29,260
心理臨床家は、クライエントのプライバシー保護を含めた職業倫理を遵守することが求められます。また、研究や訓練を行い日々研鑽に励むことが重要です。この巻では、心理臨床の倫理・研究・訓練について解説します。
Index
●イントロダクション
●心理臨床の倫理
〇倫理綱領の概要
〇臨床業務における倫理
〇事例による倫理への理解
●心理臨床の研究
〇事例研究法と調査研究法
〇研究と倫理
●心理臨床の訓練
〇臨床力の訓練
〇スーパービジョンの実際
●エンディング -
- 定価:¥30,800
- オンラインショップ価格:¥29,260
~ 認知症がある患者の行動の意味を理解する~
アルツハイマー型認知症の患者事例を用いて、認知症のある方がなぜ治療を拒否してしまうのかを探ります。
認知症のある方の視点映像を通じて、その行動や心理を理解し、適切な関わり方やケアの一例を解説します。
また、認知症ケアの在り方を深めるためのテストも付属しています。
※認知症の概要がわかる共通ムービー付きIndex
●シリーズ共通movieイントロダクション
〇認知症高齢者の急性期病院の看護について
〇認知症の分類と症状
●アルツハイマー型認知症とその症状から生じる看護課題
●本人視点から学ぶ認知症看護
〇3人称視点
〇看護師視点
〇認知症高齢者視点
〇適切なケアの実践(一例) -
- 定価:¥30,800
- オンラインショップ価格:¥29,260
~ せん妄のリスク因子の理解と対応~
術後の血管性認知症が疑われる患者の事例を用いて、せん妄の理解や身体拘束について解説します。
患者の視点を通じて、その状態や心理を理解し、身体拘束の回避や認知症が疑われる患者への適切なケアの一例を解説します。
また、理解を深めるためのテストも付属しています。
※認知症の概要がわかる共通ムービー付きIndex
●シリーズ共通movieイントロダクション
〇認知症高齢者の急性期病院の看護について
〇認知症の分類と症状
●血管性認知症とせん妄の関係と看護課題
●本人視点から学ぶ認知症看護
〇3人称視点
〇看護師視点
〇高齢者視点(認知症の疑いあり)
〇適切なケアの実践(一例) -
- 定価:¥30,800
- オンラインショップ価格:¥29,260
産科退院後の生活
初産婦の聖子さんは、本日、産科を退院し自宅に帰ってきました。退院指導の助産師にさまざまな不安をうけています。この事例では、初めての子育てをする聖子さんが抱えている不安を中心に退院後の生活場面を紹介します。Index
●退院の日(自宅):産後5日
●退院の日(夜)
●深夜1時半
●翌日(19時):産後6日 -
- 定価:¥30,800
- オンラインショップ価格:¥29,260
家族との生活
初産婦の聖子さんは、二世帯住宅で夫の両親と暮らしています。子育てに対する不安を抱え、義父母との関わりではプレッシャーを感じています。この事例では、授乳や赤ちゃんの世話に追われ、疲れと不安が蓄積していく場面や、また初めての孫を持った義父母との関わりの場面も紹介します。
Index
●産後16日(深夜)
●産後17日(朝)
●産後17日(夜)
●産後18日(夕方)
●産後18日(深夜) -
- 定価:¥30,800
- オンラインショップ価格:¥29,260
産科入院中の生活
初産婦の聖子さんは、男児を出産しました。母子ともに健康で産後の産院での生活が始まりますが、思うように授乳ができずストレスを感じています。この事例では、授乳支援や搾乳支援の場面、退院調整の場面、またオムツ交換や沐浴、臍処置に不安を感じている場面を紹介します。
Index
●場面1 出産直後の家族対面
●場面2 オムツ交換:産後1日
●場面3 授乳支援:産後1日
●場面4 搾乳支援:産後2日
●場面5 退院準備:産後3日
●場面6 沐浴指導:産後3日
●場面7 授乳の方針:産後3日
●場面8 臍処置:産後4日
●場面9 退院指導:産後4日 -
- 定価:¥30,800
- オンラインショップ価格:¥29,260
Index
●生物学的存在としての人間
〇生命の維持
〇人間の活動
●自然と人間
〇生命圏:地球
〇エネルギーの利用
●環境と人間
〇環境変化の影響
〇環境への適応
●ライフサイクル-成長と発達-
〇乳児期・幼児期
〇学童期~成人期
●ライフサイクル-エイジングと死-
〇エイジング
〇死
●確認問題へ(全5問) -
- 定価:¥30,800
- オンラインショップ価格:¥29,260
- 006:生体の構成単位
- 007:遺伝情報と細胞分裂
- 008:形質の発現
- 009:タンパク質
- 010:組織と器官
Index
●生体の構成単位
〇細胞の基本構造
〇細胞膜の構造と機能
●遺伝情報と細胞分裂
〇DNAの構造
〇体細胞分裂
●形質の発現
〇転写
〇翻訳
●タンパク質
〇機能タンパク質
〇構造タンパク質
●組織と器官
〇筋組織
〇上皮組織
〇神経組織
〇結合組織
●確認問題へ(全5問) -
- 定価:¥30,800
- オンラインショップ価格:¥29,260
- 011:神経系の発生と分類
- 012:神経伝達のしくみ
- 013:大脳
- 014:小脳・間脳
- 015:脳幹
Index
●神経系の発生と分類
〇神経系の発生
〇髄膜と脳脊髄液
〇神経系の分類
●神経伝達のしくみ
〇細胞膜の興奮伝導
〇シナプスの興奮伝達
●大脳
〇大脳の構造
〇大脳皮質の機能局在
●小脳・間脳
〇小脳
〇間脳
●脳幹
〇中脳
〇延髄
〇橋
●確認問題へ(全5問) -
- 定価:¥30,800
- オンラインショップ価格:¥29,260
- 016:脳への血液供給
- 017:脳神経
- 018:脊髄と脊髄神経
- 019:自律神経
- 020:反射
Index
●脳への血液供給
〇脳血管障害
〇血液脳関門(BBB)
●脳神経
〇第I・II脳神経
〇第III~VIII脳神経
〇第IX~XII脳神経
●脊髄と脊髄神経
〇脊髄(神経路)
〇脊髄神経
●自律神経
〇自律神経の機能
〇自律神経の構成と分布
●反射
〇体性反射
〇自律神経反射
〇反射テスト
●確認問題へ(全5問) -
- 定価:¥30,800
- オンラインショップ価格:¥29,260
- 021:睡眠
- 022:意識の発現
- 023:記憶と学習
- 024:言語と左右脳
- 025:情動
●睡眠
〇睡眠覚醒パターン
〇睡眠時の脳波
●意識の発現
〇意識発現のしくみ
〇意識障害の評価
●記憶と学習
〇記憶の種類
〇記憶のメカニズム
〇学習と報酬系
●言語と左右脳
〇言語の理解と発話
〇左脳と右脳
●情動
〇情動反応
〇情動のメカニズム
〇神経伝達物質と情動
●確認問題へ(全5問) -
- 定価:¥30,800
- オンラインショップ価格:¥29,260
- 026:視覚 - 光受容機能と視細胞 -
- 027:視覚 - 眼の調節機能 -
- 028:聴覚と平衡感覚
- 029:味覚と嗅覚
- 030:体性感覚と内臓感覚
Index
●視覚-光受容機能と視細胞-
〇光受容機能
〇視細胞の働き
〇色覚
●視覚-眼の調整機能-
〇焦点距離の調節
〇眼球運動
●聴覚と平衡感覚
〇聴覚
〇音の周波数
〇平衡感覚
●味覚と嗅覚
〇味覚
〇嗅覚
●体性感覚と内臓感覚
〇体性感覚
〇内臓感覚
●確認問題へ(全5問) -
- 定価:¥30,800
- オンラインショップ価格:¥29,260
- 031:随意運動の発現
- 032:骨の構造と成長
- 033:骨の連結
- 034:骨格筋の収縮機構
- 035:筋収縮のエネルギーと特性
Index
●随意運動の発現
〇運動器
〇運動の発現と制御
●骨の構造と成長
〇骨の構造と機能
〇骨の成長と代謝
●骨の連結
〇関節
〇結合
●骨格筋の収縮機構
〇骨格筋の収縮装置
〇骨格筋収縮のしくみ
●筋収縮のエネルギーと特性
〇筋運動のエネルギー
〇骨格筋収縮の特性
●確認問題へ(全5問) -
- 定価:¥30,800
- オンラインショップ価格:¥29,260
- 036:体幹の骨格と筋
- 037:上肢の骨格と筋
- 038:下肢の骨格と筋
- 039:頭頸部の骨格と筋
- 040:運動の生理
Index
●体幹の骨格と筋
〇脊柱と胸郭
〇体幹の筋
●上肢の骨格と筋
〇上肢の骨格
〇上肢の筋と運動
●下肢の骨格と筋
〇下肢の骨格
〇下肢の筋と運動
●頭頸部の骨格と筋
〇頭蓋骨
〇頭頸部の筋
●運動の生理
〇運動時の生理機能
〇運動の効果
●確認問題へ(全5問) -
- 定価:¥30,800
- オンラインショップ価格:¥29,260
- 041:血液の働きと成分
- 042:赤血球
- 043:白血球と血小板
- 044:血液の凝固と線溶
- 045:血液型
Index
●血液の働きと成分
〇血液の働き
〇血液の成分と性質
●赤血球
〇赤血球の機能
〇赤血球の一生
●白血球と血小板
〇白血球
〇血小板
●血液の凝固と線溶
〇止血のしくみ
〇血液凝固因子
●血液型
〇ABO式とRh式
〇血液型の判定
●確認問題へ(全5問) -
- 定価:¥30,800
- オンラインショップ価格:¥29,260
- 046:心臓の構造
- 047:血液の循環と心臓の発生
- 048:心筋と冠循環
- 049:刺激伝導系と自動能
- 050:心臓の検査
Index
●心臓の構造
〇心房と心室
〇心臓の弁
●血液の循環と心臓の発生
〇血液の循環
〇心臓の発生と胎児循環
●心筋と冠循環
〇心筋
〇冠循環
●刺激伝導系と自動能
〇刺激伝導系
〇自動能
●心臓の検査
〇心電図
〇心音
〇胸部X線撮影
●確認問題へ(全5問) -
- 定価:¥30,800
- オンラインショップ価格:¥29,260
- 051:循環圧力と測定
- 052:血圧と血流量の調節
- 053:動脈
- 054:毛細血管と静脈
- 055:リンパ系
Index
●循環圧力と測定
〇心内圧と血圧
〇血圧測定と心内圧測定
●血圧と血流量の調節
〇血圧の調節
〇血流量の調節
●動脈
〇動脈の分岐
〇動脈の構造と病変
●毛細血管と静脈
〇毛細血管
〇静脈
●リンパ系
〇リンパ管
〇リンパ性器官
●確認問題へ(全5問) -
- 定価:¥30,800
- オンラインショップ価格:¥29,260
- 056:呼吸器系 - 気道 -
- 057:呼吸器系 -肺-
- 058:呼吸運動とその調節
- 059:ガス交換とガスの運搬
- 060:呼吸機能の検査
Index
●呼吸器系 ‐気道‐
〇上気道
〇下気道
●呼吸器系 ‐肺‐
〇肺の構造
〇肺胞
●呼吸運動とその調節
〇呼吸運動
〇呼吸の調節
●ガス交換とガスの運搬
〇ガス交換
〇ガスの運搬
〇換気と血流
●呼吸機能の検査
〇肺気量
〇換気機能
〇血液ガスと呼吸音
●確認問題へ(全5問) -
- 定価:¥30,800
- オンラインショップ価格:¥29,260
- 061:栄養のニード
- 062:口腔・咽頭・食道
- 063:胃
- 064:小腸
- 065:大腸
Index
●栄養のニード
〇食欲
〇成長と栄養
●口腔・咽頭・食道
〇口腔
〇咽頭と食道
●胃
〇胃の構造
〇胃の働き
●小腸
〇十二指腸
〇空腸と回腸
●大腸
〇大腸の構造
〇大腸の働き
〇排便
●確認問題へ(全5問) -
- 定価:¥30,800
- オンラインショップ価格:¥29,260
- 066:肝臓
- 067:胆道系
- 068:膵臓
- 069:腹膜
- 070:栄養の消化・吸収
Index
●肝臓
〇肝臓の構造
〇肝臓の機能
●胆道系
〇胆汁の生成と放出
〇胆汁の役割と異常
●膵臓
〇膵臓の外分泌
〇膵臓の内分泌
●腹膜
〇腹膜の構造と機能
〇腹膜透析と腹水
●栄養素の消化・吸収
〇口腔・胃での消化
〇小腸での消化・吸収 -管腔内消化‐
〇小腸での消化・吸収 -膜消化‐
●確認問題へ(全5問) -
- 定価:¥30,800
- オンラインショップ価格:¥29,260
- 071:代謝とは
- 072:酵素と補酵素
- 073:糖の代謝
- 074:脂質の代謝
- 075:タンパク質の代謝
Index
●代謝とは
〇同化と異化
〇三大栄養素の代謝
●酵素と補酵素
〇酵素とは
〇補酵素とは
●糖質の代謝
〇エネルギー産生
〇糖新生
●脂質の代謝
〇脂質の体内輸送
〇脂肪酸の代謝
〇コレステロールの代謝
●タンパク質の代謝
〇アミノ産の代謝
〇アンモニアの処理
〇アミノ産の合成と利用
●確認問題へ(全5問) -
- 定価:¥30,800
- オンラインショップ価格:¥29,260
- 076:腎臓
- 077:尿路系 - 排尿 -
- 078:尿からの情報
- 079:腎機能の評価
- 080:体液平衡
Index
●腎臓 -糸球体-
〇尿の生成
〇糸球体濾過
●腎臓 -尿細管-
〇再吸収と分泌
〇腎臓とホルモン
●尿路系 -排尿-
〇尿の輸送
〇尿の貯蔵と排泄
●糸球体濾過量
〇傍糸球体装置
〇クリアランス
●尿からの情報
〇尿の成分と性状
〇尿の異常と疾患
●確認問題へ(全5問) -
- 定価:¥30,800
- オンラインショップ価格:¥29,260
- 081:ホルモン
- 082:下垂体ホルモン
- 083:甲状腺ホルモン
- 084:副腎皮質ホルモン
- 085:膵臓のホルモン
Index
●ホルモン
〇内分泌腺とホルモン
〇ホルモンの作用機序
●下垂体ホルモン
〇下垂体と視床下部
〇前葉ホルモン
〇後葉ホルモン
●甲状腺ホルモン
〇甲状腺ホルモンの産生と作用
〇甲状腺ホルモンの分泌調節
●副腎皮質ホルモン
〇副腎皮質の構造と機能
〇電解質コルチコイドの作用
〇糖質コルチコイドの作用
●膵臓のホルモン
〇ランゲルハンス島
〇血糖値の調節
●確認問題へ(全5問)